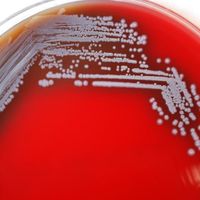

infection
Latest
link to article
Scientists Have Found COVID-19's Inside Man, And They Know How To Shut Him Up
link to article
Scientists Have Found COVID-19's Inside Man, And They Know How To Shut Him Up
link to article
Watch A Virus Infecting A Cell Caught On Video For The First Time Ever
link to article
Watch A Virus Infecting A Cell Caught On Video For The First Time Ever